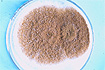
Siehe Vergroesserung 4,7

Abb.4,1 Aspergillose
|
 Abb.4,2 Aspergillose
|
 Abb.4,3 Aspergillose
|
 Abb.4,4 Aspergillose
|
 Abb.4,5 Aspergillose
|
 Abb.4,6 Aspergillose
|
Abb.4,7 Aspergillose
|
 Abb.4,8 Aspergillose
|
 Abb.4,9 Aspergillose
|
 Abb.4,10 Aspergillose
|
 Abb.4,11 Aspergillose
|
 Abb.4,12 Aspergillose
|
 Abb.4,13 Aspergillose
|
 Abb.4,14 Aspergillose
|
 Abb.4,15 Aspergillose
|
 Abb.4,16 Aspergillose
|
 Abb.4,17 Aspergillose
|
|